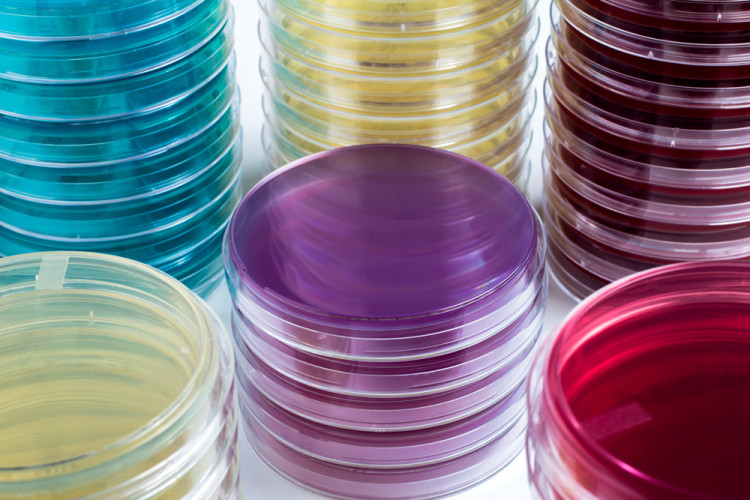

News
14.10.2021 - Labor
Nährmedienherstellung und Nährmedienprüfung beim BAV Institut
Zukünftig Teil der Akkreditierungsurkunde und NEU beim BAV Institut: Nährmedienherstellung und –prüfung gemäß DIN EN ISO 11133.
Im Rahmen eines kürzlich durchgeführten Audits wurde obige Qualifikation unseres Instituts bestätigt. Damit sind wir eines von ganz wenigen Prüflaboren, das neben den Untersuchungen auch für die Herstellung und Prüfung von Nährmedien gemäß der ISO 11133 sowie dem Ph. Eur. (Europäisches Arzneibuch) akkreditiert ist. Wir können damit ab sofort unseren Kunden und unseren Partnerlaboren hochwertige Nährmedien mit entsprechendem Prüfzertifikat zur Verfügung stellen.
Sie möchten bestimmte Nährmedien beziehen ? Sie haben Fragen zu den Medien und den damit verbundenen Prüfungen ? Melden Sie sich bei Ihrem BAV Institut – wir freuen uns auf Ihre Nachricht.